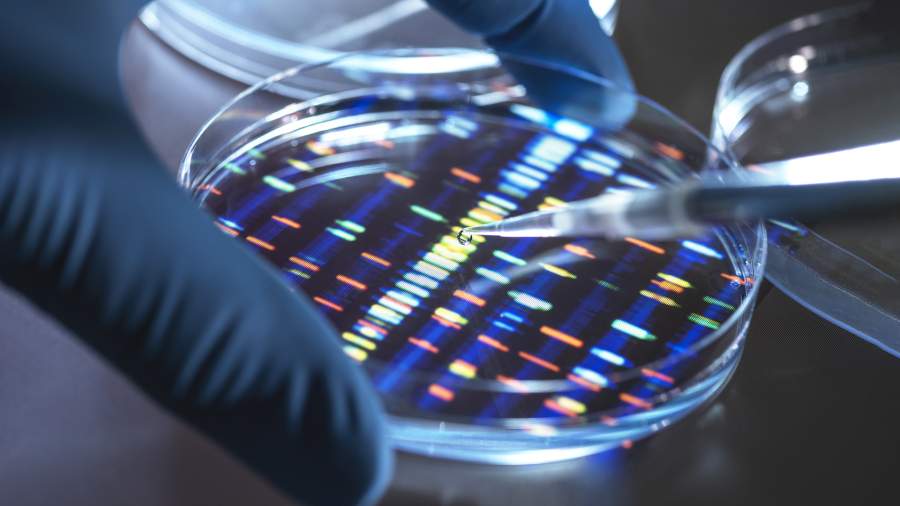

Specific materials: quantum calculations will accelerate the creation of drugs and batteries
- Статьи
- Science and technology
- Specific materials: quantum calculations will accelerate the creation of drugs and batteries
Russian researchers have improved quantum algorithms to use them to study molecules ten times faster. This will make it possible to create new materials for pharmaceuticals, the chemical industry, materials science, energy and other industries, the developers told Izvestia. In the future, such calculations will become a working tool for solving real-world problems in science and industry: the search for promising drug molecules, the design of new catalysts to accelerate chemical reactions, the development of efficient materials for batteries and fuel cells, and so on.
Quantum algorithms for new materials
Researchers at NUST MISIS and Kazan (Volga Region) Federal University have improved quantum algorithms to study molecules for the pharmaceutical, chemical, and other industries ten times faster. The Ministry of Education and Science told Izvestia about this. The method has already been adapted to the capabilities of modern devices and brings quantum computing closer to solving real industrial problems. Optimization of the variational algorithm for searching for eigenvalues has significantly reduced the number of quantum operations for modeling molecules.
According to scientists, chemistry and materials science are increasingly facing challenges that require accurate calculations of the behavior of electrons in molecules. Such calculations help to create new materials, but conventional computers are not able to simulate complex molecules with the required degree of accuracy — even supercomputers cannot always cope with the amount of calculations.
Scientists call a variational quantum algorithm for searching for eigenvalues one of the most promising calculation methods for such problems today. It is adapted to run on modern quantum computers, the precise operation of which is hindered by any unwanted external influence. It allows you to find the most stable state of a molecule step by step using the collaboration of a quantum and classical computer. Although the former have a number of advantages, for practical applications in chemistry, the main barrier has always been too complex circuits and a huge number of two-qubit operations, which most often produce errors.
The researchers have proposed ways to optimize the variational quantum algorithm, which can significantly reduce the resources needed to simulate real organic molecules, while maintaining high accuracy.
"The research has not only reduced the complexity of quantum calculations, but has also made it possible to simulate organic molecules under conditions that match the potential of modern quantum computers. In the future, such calculations will become a working tool for solving real—world problems in science and industry: the search for promising drug molecules, the design of new catalysts to accelerate chemical reactions, the development of efficient materials for batteries and fuel cells, and so on," Alexey Fedorov, PhD, director of the Institute of Physics and Quantum Engineering, told Izvestia.
The essence of the work lies in the fact that scientists have developed a new strategy: to reduce the number of measurements, they excluded electrons from calculations that do not affect chemical properties, reduced the number of qubits, grouped operators and simplified quantum circuits. First, these changes were tested on simple molecules, and then applied to more complex ones — methylamine and formic acid, which play an important role in biology, as well as in the pharmaceutical, textile and food industries. As a result, the number of two-qubit operations, which previously reached 600 thousand, was reduced to about 12 thousand, while the accuracy of calculations remained at the required level.
Application of a new quantum algorithm
Now it is important not only to develop quantum computers, but also to find algorithms that will unlock their potential in the best possible way. None of the modern researchers expects that there will be an instant transition to quantum computers capable of solving super-complex tasks, Vladimir Egorov, deputy director of the ITMO National Center for Quantum Internet, told Izvestia. The development proceeds in stages: first, simpler tasks are taken that are inaccessible to electronic computers or are solved more slowly, then the complexity gradually increases.
— The presented study is an excellent example of this approach. It is especially valuable that the work is focused on pharmaceuticals — it is most often named among the areas that will receive the fastest, most significant and significant benefits from quantum computing. The authors have chosen the right direction, and their successes are important for the entire industry," the expert noted.
Scientists have achieved values close to the expected values for approximations, the approximations themselves also sound reasonable, so the method is promising, commented Igor Mezentsev, researcher at the NTI Center for Digital Materials Science: New Materials and Substances at the Bauman Moscow State Technical University.
"In particular, by using physically based approximations, it is possible to significantly (by one or two orders of magnitude) reduce the number of operations that carry a high probability of error, without loss of accuracy," he said.
The results of the study are also interesting for infochemistry: thanks to the optimization of quantum algorithms, molecular modeling has become more efficient," said Ekaterina Skorb, Director of the ITMO Scientific and Educational Center for Infochemistry. The development is potentially interesting for using quantum simulations in molecular design tasks, especially with organic compounds important for pharmaceuticals and materials science, she noted.
The details of the study are published in the scientific journal Quantum Reports. The work was carried out within the framework of the strategic technological project of NUST MISIS "Quantum Internet" under the program "Priority 2030".
Переведено сервисом «Яндекс Переводчик»
